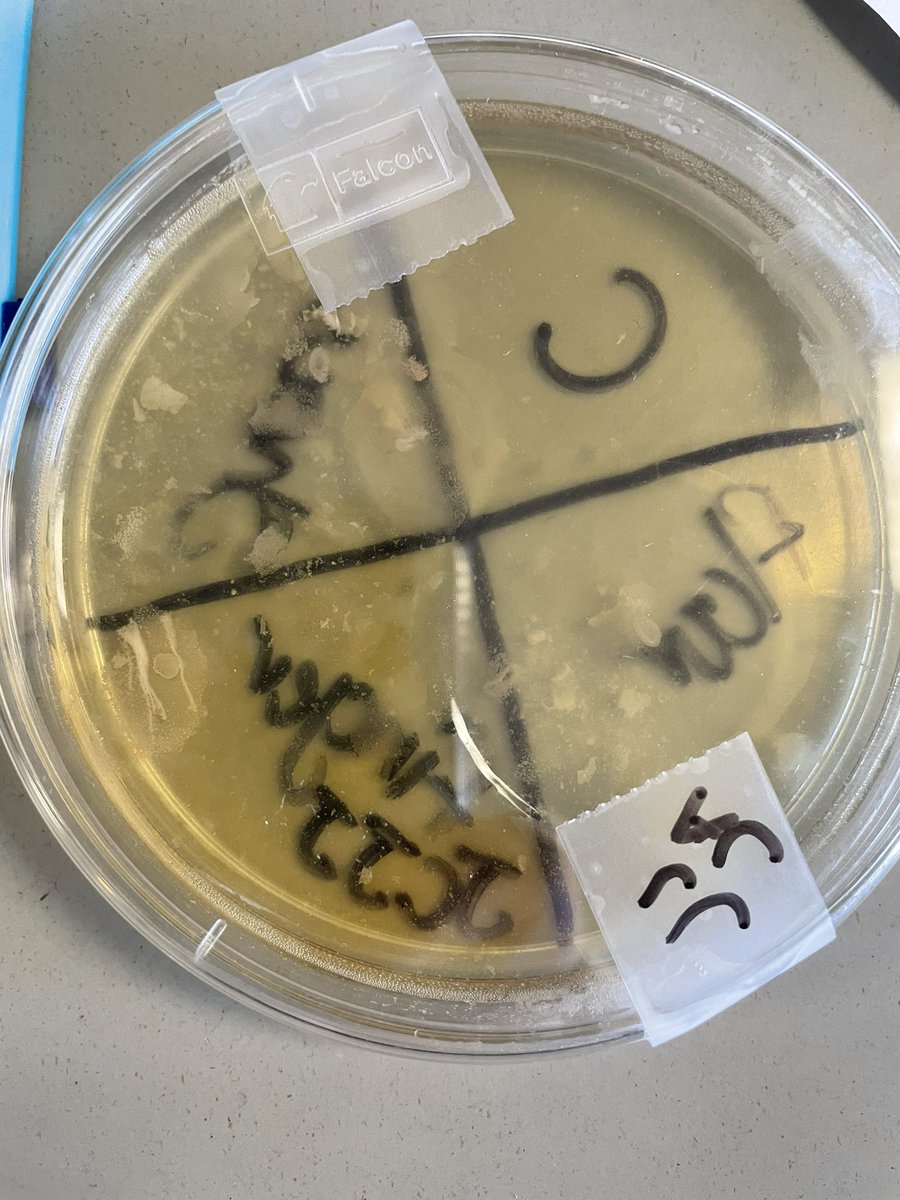
How do biohazards effect human health? We swabbed surfaces around the room to see how clean things really are. #envirosci

Brooke Quadrini
@quadrinibrooke
ID: 1074752054667694080
17-12-2018 19:43:52
425 Tweet
153 Followers
230 Following




I might be biased but I think LaVergne High School has the coolest swim team around 🏊♀️



Finished out the day before break making different circuits in physics!!⚡ LaVergne High School #Science



Cranking out the microscopes to see all the bacteria we've been growing this week at LaVergne High School 🤗🧫 #Science


My LaVergne High School EnvSci classes were able to dissect rats as an enrichment activity this week, and they did such a great job!! 💙🐀 #sciencerules






Roo got a blow out today after his bath! He was such a sweet boy today and really enjoyed having him! Thank you Brooke Quadrini! 💙


My first time watching a wrestling match and LaVergne High School is keeping it exciting! So proud of these students & the passion and effort they bring to the mat 💙🤍


The Natural Selection activity was a huge success and lots of fun for my LaVergne High School biology classes! (We love competition) 💙🧬


The Wolverine Bn putting on a great display of skill this morning!! So proud of our LaVergne High School students 💙🤍


Congratulations to the LHS JROTC Wolverine Battalion on another big win at the Rutherford County Drill competition. 1st place Dual Ex. & Color Guard and 1st Place overall in the County. LaVergne High School